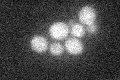
YDR087C
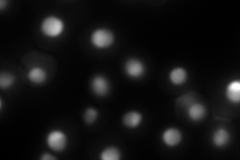
YDR087C
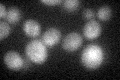
YDR087C

View description
Essential evolutionarily conserved nucleolar protein necessary for biogenesis of 60S ribosomal subunits and processing of pre-rRNAs to mature rRNAs, associated with several distinct 66S pre-ribosomal particles
Localization:
Intensity:
Fold change:
Significance:
-
C’ GFP library in SD
below threshold16.28 -
N' NOP1pr-GFP in SD

nucleolus219.535 -
N' TEF2pr-mCherry in SD
nucleus,nucleolus283.924 -
N' NATIVEpr-GFP in SD

nucleus,nucleolus119.058 -
N' TEF2pr-VC and Cyto-VN in SD

nucleus62.098 -
C’ GFP library in SD+DTT
cytosol16.31No -
C’ GFP library in SD+H2O2

cytosol14.220.87No -
C’ GFP library in Starvation Media

cytosol15.520.95No -
C’ GFP library on the background of Pup2-DaMP

below threshold -
C’ GFP library on the background of CCT mutant

below threshold16.54781.016No
